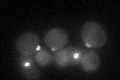
YHR023W
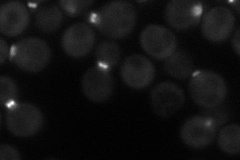
YHR023W
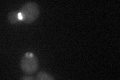
YHR023W
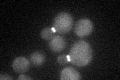
YHR023W

View description
Type II myosin heavy chain, required for wild-type cytokinesis and cell separation; localizes to the actomyosin ring; binds to myosin light chains Mlc1p and Mlc2p through its IQ1 and IQ2 motifs respectively
Localization:
Intensity:
Fold change:
Significance:
-
C’ GFP library in SD
bud neckN/A -
N' NOP1pr-GFP in SD
bud neck47.994 -
N' TEF2pr-mCherry in SD

bud neckN/A -
N' NATIVEpr-GFP in SD

bud neck23.9048 -
N' TEF2pr-VC and Cyto-VN in SD

bud neck33.6217 -
C’ GFP library in SD+DTT
bud neck19.140.83No -
C’ GFP library in SD+H2O2
bud neck28.431.24No -
C’ GFP library in Starvation Media

cytosol17.450.76No -
C’ GFP library on the background of Pup2-DaMP

bud neck -
C’ GFP library on the background of CCT mutant

bud neck22.55450.985669No
